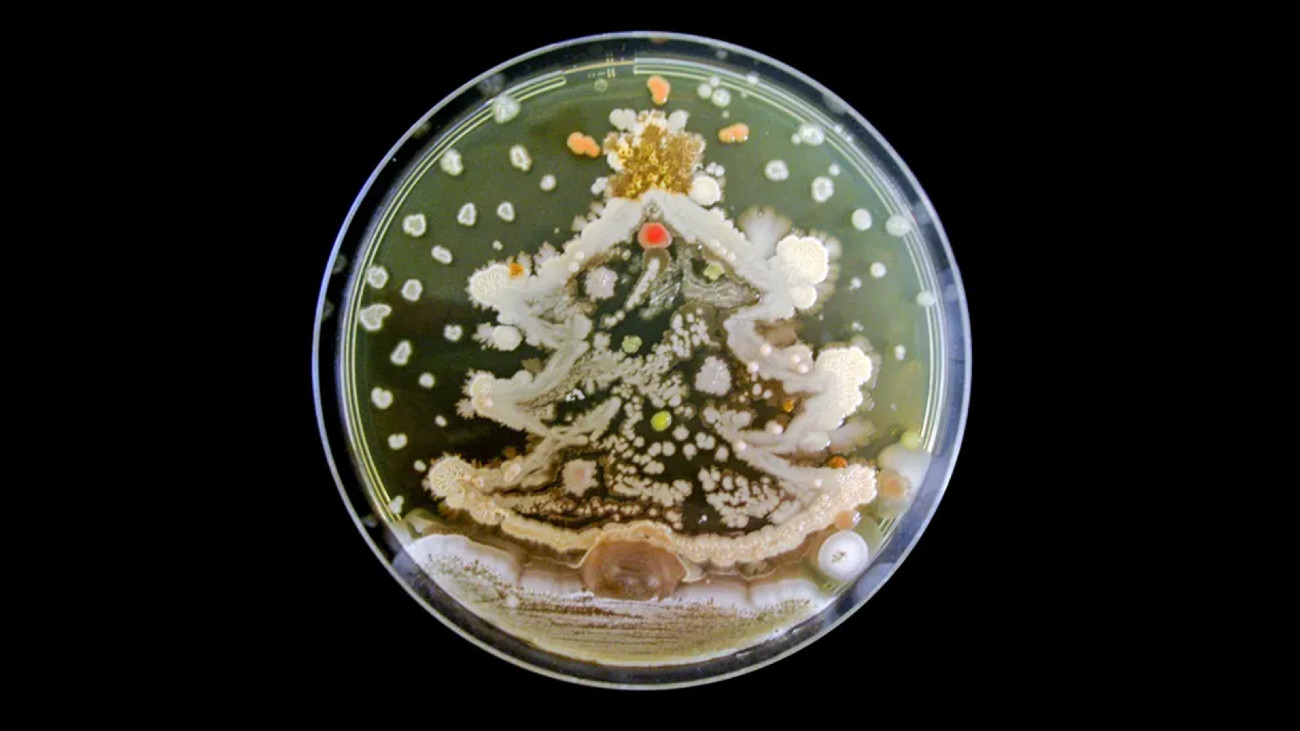

Ben je geïnteresseerd in de wereld van wetenschap & technologie en wil je hier graag meer over lezen? Word dan lid van KIJK!
Om je werkweek goed te starten, elke maandag een tof wetenschappelijk of technologisch beeld op onze site. Deze keer: een kerstboom van gekweekte bacteriën.
In labs kweken microbiologen geregeld bacteriën in een petrischaal met een voedingsbodem van agar. Meestal is dit nodig voor hun onderzoek, maar in december 2014 maakte de toenmalig masterstudent Rositsa Tashkova deze feestelijke, maar niet per se nuttige, bacteriekerstboom om in de feeststemming te komen.
Lees ook:
- Picture Perfect: monsterlijk wezen in oceaan
- Picture Perfect: James Webb kiekt verste ster in het heelal
Kweekkerstboom
De witte en crèmekleurige stipjes zijn kolonies van het bacteriegeslacht Bacillus. De andere kleuren zijn besmettingen van willekeurige bacteriën uit het lab die tijdens de kweeksessie per ongeluk op de voedingsbodem terecht zijn gekomen.
Tashkova stuurde haar foto op naar de American Society for Microbiology (ASM) die het vervolgens deelde op social media. Nadat de bacteriekerstboom viral ging, besloot de ASM een agarkunstwedstrijd te organiseren. Er zijn nu meer dan tweehonderd inzendingen per jaar.
Dit jaar was het thema van de competitie: je favoriete microbioloog. Tussen de winnaars zaten portretten van onder andere Rosalind Franklin, Fanny Hesse en Odo Bujwid. Je maakt vast niet iedereen blij met een bacterieportret, maar deze drie wetenschappers zouden het fantastisch gevonden hebben.
Bronnen: ASM, National Geographic UK
Beeld: Rositsa Tashkova